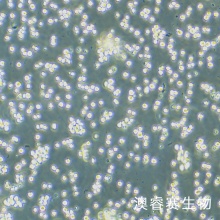
SKM-1细胞；人骨髓增生异常综合征细胞

|
一、细胞基本属性
|
|
|
细胞名称
|
SKM-1细胞
|
|
细胞别称
|
SKM1;人骨髓增生异常综合征细胞
|
|
商品货号
|
ORC1498
|
|
种属来源
|
人
|
|
年龄性别
|
男性;76岁
|
|
组织来源
|
外周血
|
|
生长特性
|
悬浮细胞
|
|
细胞形态
|
淋巴母细胞样;圆形,单个细胞
|
|
背景简介
|
1989年,从一名76岁患有骨髓增生异常综合征(MDS)的急性单核细胞白血病(AMLM5)患者的外周血中获得。
|
|
生物安全等级
|
BSL-1
|
|
细胞规格
|
1×106cells/T25培养瓶或者1mL冻存管包装
|
|
支原体检测
|
无
|
|
培养基
|
1640+20%FBS+1%双抗
|
|
培养条件
|
气相:空气,95%;CO2,5%, 温度:37℃
|
|
冻存条件
|
冻存液:55% 基础培养基+40%FBS+5%DMSO 温度:液氮
|